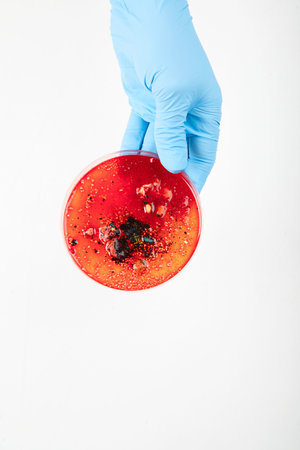

写真素材 - Hand in blue glove holding petri dish with bacterium. Microbiology science. Top view.
作品情報
Hand in blue glove holding petri dish with bacterium. Microbiology science. Top view.
- ID:223582404
- 作品種別:写真
- 作者名:Tatjana Baibakova
キーワード
- analysis
- background
- bacterial
- bacteriology
- biology
- biotechnology
- blue
- chemical
- chemistry
- clean
- cosmetic
- culture
- development
- discovery
- disease
- dish
- epidemic
- equipment
- experiment
- fungal
- genetic
- glove
- growth
- hygiene
- infection
- lab
- laboratory
- medical
- micro
- microbe
- microbiology
- petri
- research
- safety
- science
- scientific
- study
- test
- treatment
- virus
類似作品
Female doctor b...
cropped view of...
Man Wearing Glo...
Body language, ...
Woman doctor is...
Discarded lying...
The gloved hand...
Doctors hands i...
Colorful surgic...
Doctor's hand i...
Profile side vi...
Blue latex glov...
Lifestyle conce...
Heart made of l...
Woman in blue m...
Colorful surgic...
Home workouts o...
Displaying Empt...
Displaying Empt...
Using hands in ...
Ok sign. Hand w...
Nurse or cosmet...
Close up of fem...
hand protected ...
Dental mold den...
Hand in disposa...
Putting on medi...
Crop close up o...
Prevention of i...
Doctor hand wit...
Human hand in l...
female doctor i...
a hand in a blu...
Mother holding ...
A woman hand in...
Fist of right m...
Hand in blue pr...
Hands of man pu...
Close-up view o...
Profile side vi...
Displaying Empt...
insulated hand ...
hand in a rubb...
A blue medical ...
Displaying Empt...
Prevention of i...
Male hand in bl...
blue plastic ba...